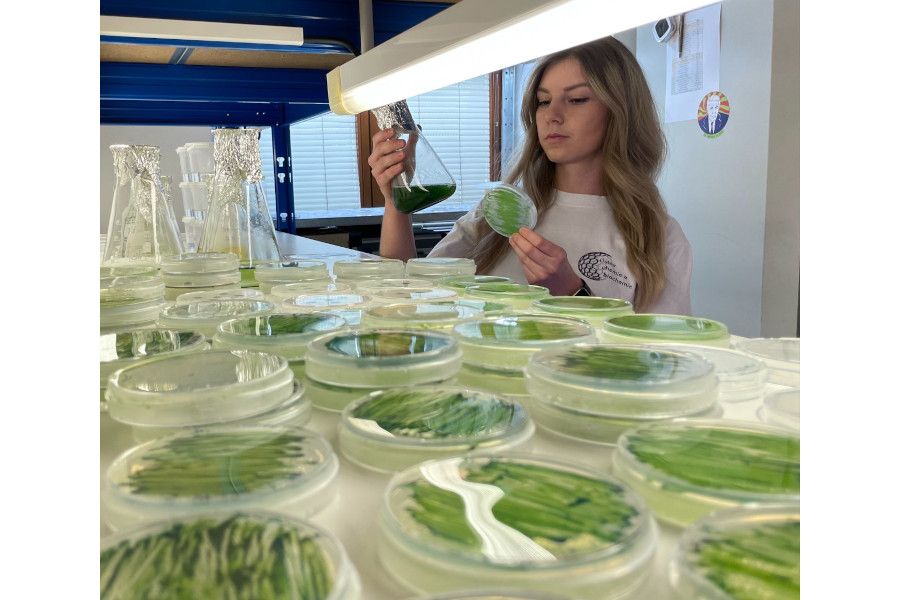
Řasy s umělou inteligencí by do budoucna mohly čistit odpadní vodu

Do ČR poprvé zamíří BioEquity, největší evropská konference pro biotech investory
Praha se příští rok stane centrem evropského biotechnologického investičního světa. Poprvé v historii bude hostit prestižní mezinárodní konferenci BioEquity Europe. Česká republika tak bude první zemí ze střední a východní Evropy, kam tato...
více »